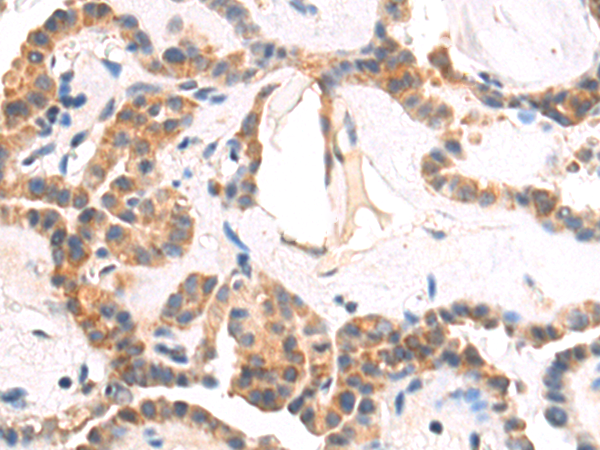

-
分类: 科研抗体货号: P08272别名: EIF-4B; PRO1843应用: IHC反应种属: Human, Mouse
-
分类: 科研抗体货号: P08243别名: BP1; DLX7; DLX8; DLX9应用: WB反应种属: Human, Mouse
-
分类: 科研抗体货号: P08260别名:应用: WB,IHC反应种属: Human, Mouse
-
分类: 科研抗体货号: P08270别名: EIF3S3; eIF3-p40; eIF3-gamma应用: WB,IHC反应种属: Human, Mouse, Rat
-
分类: 科研抗体货号: P08259别名: ECE应用: WB,IHC反应种属: Human, Mouse
-
分类: 科研抗体货号: P08269别名: CRI1; EID-1; RBP21; PTD014; C15orf3; PNAS-22; IRO45620应用: IHC反应种属: Human
-
分类: 科研抗体货号: P08291别名: PICH; RAD26L应用: IHC反应种属: Human
-
分类: 科研抗体货号: P08268别名: LBP; ECHD; LBFP; PBFE; L-PBE应用: WB,IHC反应种属: Human, Mouse
-
分类: 科研抗体货号: P08288别名:应用: IHC反应种属: Human, Mouse
-
分类: 科研抗体货号: P08267别名: eEF-2K; CaMKIII; HSU93850应用: WB,IHC反应种属: Human, Mouse, Rat

鄂公网安备42018502007531号
鄂公网安备42018502007531号

